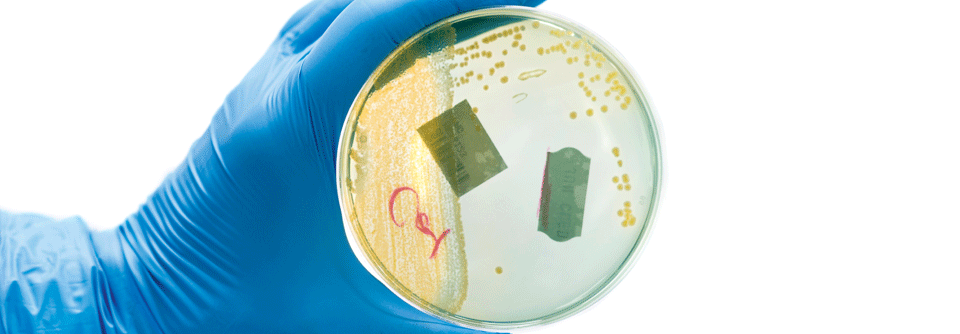

Niere im Alter So relevant sind Restharn und Bakteriurie
 Mit dem Alter kommen auch vermehrt gesundheitliche Probleme. Ein geriatrisches Assessment zur Abschätzung der Lage ist daher sinnvoll.
© VectorMine – stock.adobe.com
Mit dem Alter kommen auch vermehrt gesundheitliche Probleme. Ein geriatrisches Assessment zur Abschätzung der Lage ist daher sinnvoll.
© VectorMine – stock.adobe.com
Bei geriatrischen Patienten mit urologischen Leiden sollte man nicht nur auf die GFR schauen, betonte Prof. Dr. Andreas Wiedemann von der Klinik für Urologie am Evangelischen Krankenhaus in Witten. Der Referent riet dazu, ein geriatrisches Assessment durchzuführen. Ein einfaches Screening-Instrument ist der ISAR (identification of seniors at risk) mit sechs Fragen. Menschen mit einem positiven ISAR sind nicht nur älter und kränker – sie haben auch ein deutlich erhöhtes Risiko für Stürze, Dekubitus und Mangelernährung.
Ein häufiges Problem bei älteren urologischen Patienten stellt die Einnahme oraler Antikoagulanzien dar. Oft kümmert sich bei ihnen keiner um die Abklärung einer Makrohämaturie, die vorschnell allein den Gerinnungshemmern zugeschrieben wird. Auch bei antikoagulierten Patienten steckt in rund 20 % der Fälle ein Tumor dahinter.
Restharn und Bakteriurie brauchen im Alter dagegen nicht beunruhigen. Macht der Restharn keine weiteren Probleme, kann man ihn bei Hochbetagten ruhig belassen. Von einer Bakteriurie geht in der Regel auch kein Gefährdungspotenzial aus.
Nebenwirkungen am Harntrakt häufig
Problematisch sind die im Alter bei Blasenfunktionsstörungen eingesetzten anticholinergen Medikamente, sie gehen mit einem erhöhten Demenzrisiko einher. Vorsicht ist bei bereits bestehenden kognitiven Einschränkungen geboten. Große Probleme können auch weitere der oft zahlreich verschriebenen Medikamente bereiten. Viele von ihnen haben z.T. erhebliche Nebenwirkungen am Harntrakt.
Quelle: UroAktuell 2022